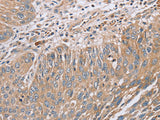
RAB8B Polyclonal Antibody Store at -20°C

RAB8B Polyclonal Antibody Store at -20°C
SKU: E-AB-13546-200
RAB8B Polyclonal Antibody Store at -20°C
| SKU # | E-AB-13546 |
| Reactivity | Human, Mouse, Rat |
| Host | Rabbit |
| Applications | IHC |
Product Details
| Isotype | IgG |
| Host | Rabbit |
| Reactivity | Human, Mouse, Rat |
| Applications | IHC |
| Clonality | Polyclonal |
| Immunogen | Synthetic peptide of human RAB8B |
| Abbre | RAB8B |
| Synonyms | 5930437D16, D330025I23Rik, FLJ38125, GTPase Rab8b, RAB 8b protein, RAB44, RAB8B, Rab8b, Ras-related protein Rab-8B, member RAS oncogene family |
| Swissprot | |
| Cellular Localization | Cell membrane. |
| Concentration | 0.4 mg/mL |
| Buffer | Phosphate buffered solution, pH 7.4, containing 0.05% stabilizer and 50% glycerol. |
| Purification Method | Affinity purification |
| Research Areas | Cancer, Signal Transduction |
| Conjugation | Unconjugated |
| Storage | Store at -20°C Valid for 12 months. Avoid freeze / thaw cycles. |
| Shipping | The product is shipped with ice pack, upon receipt, store it immediately at the temperature recommended. |
Related Reagents
| Applications | Recommended Dilution |
| IHC | 1:30-1:150 |
Background
RAB proteins, like RAB8B, are low molecular mass monomeric GTPases that localize on the cytoplasmic surfaces of distinct membrane-bound organelles. RAB proteins function in intracellular vesicle transport by aiding in the docking and/or fusion of vesicles with their target membranes.